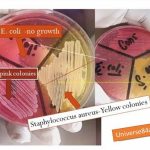
Mannitol salt agar (MSA)

Tag: MSA
MSA: Introduction, Composition, Preparation, Test Procedure, Colony Characteristics and Keynotes
 Introduction of MSA MSA stands for Mannitol Salt Agar and...
Introduction of MSA MSA stands for Mannitol Salt Agar and...
Mannitol Salt Agar (MSA): Introduction, Composition, Preparation, Uses and Colony Characteristics
Introduction of Mannitol salt agar (MSA) Mannitol Salt Agar (MSA) is...
Introduction of Mannitol salt agar (MSA) Mannitol Salt Agar (MSA) is...
